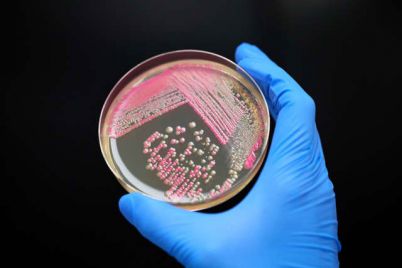
biotech-beauty-company-debut-brings-new-ingredients-products-to-skincare-market.jpg

Published: Thursday, August 28, 2025 · 12:59 PM | Updated: Thursday, August 28, 2025 · 12:59 PM
📊 548 views
🗝️ Key Points
- But the lawyers said Monarez is a presidential appointee, so only Trump can oust her."For this reason, we reject notification Dr.
- Monarez has received as legally deficient and she remains as CDC Director," attorney Mark Zaid said in the post, "We have notified the White House Counsel of our position."It's.
- were at odds over vaccine policy, The New York Times reported Wednesday, citing an anonymous administration official.Kennedy, a prominent vaccine skeptic, has taken several.
Susan Monarez, President Donald Trump’s nominee to be the Director of the Centers for Disease Control and Prevention (CDC), arrives to testify for her confirmation hearing before the Senate Committee on Health, Education, Labor, and Pensions in the Dirksen Senate Office Building on June 25, 2025 in Washington, DC.
Kayla Bartkowski | Getty Images
Lawyers for Centers for Disease Control and Prevention Director Susan Monarez said late Wednesday that she remains in the role because only President Donald Trump can fire her.
In a post on X, the lawyers said White House staff in the personnel office notified Monarez of her firing on Wednesday. But the lawyers said Monarez is a presidential appointee, so only Trump can oust her.
“For this reason, we reject notification Dr. Monarez has received as legally deficient and she remains as CDC Director,” attorney Mark Zaid said in the post, “We have notified the White House Counsel of our position.”
It’s the latest in a leadership upheaval at the CDC. The statement came hours after the White House said it had fired Monarez after she refused to resign.
In an earlier statement, Zaid said Monarez “refused to rubber-stamp unscientific, reckless directives and fire dedicated health experts” and that “she chose protecting the public over serving a political agenda.”
“For that, she has been targeted,” he said.

Monarez and Health and Human Services Secretary Robert F. Kennedy Jr. were at odds over vaccine policy, The New York Times reported Wednesday, citing an anonymous administration official.
Kennedy, a prominent vaccine skeptic, has taken several steps to change immunization policy in the U.S.
Monarez, a longtime federal government scientist, was sworn in on July 31. She is the first CDC director to be confirmed by the Senate following a new law passed during the pandemic that required lawmakers to approve nominees for the role.
At least four other top health officials announced Wednesday they were quitting the agency shortly after the Health and Human Services Department said Monarez was “no longer” CDC director in a post on X.
In an interview on Fox News on Thursday, Kennedy declined to comment on “personnel issues.” But he said the agency “is in trouble, and we need to fix it, and we are fixing it, and it may be that some people should not be working there anymore.”
He said Trump has “very, very ambitious hopes for the CDC right now.” But Kennedy said the CDC “has problems,” claiming that the agency took the “wrong” approach when it came to social distancing, masking and school closures during the Covid pandemic.
“If there’s really a deeply, deeply embedded … malaise at the agency, and we need strong leadership that will go in there and that will be able to execute on President Trump’s broad ambitions for this agency, the gold standard science and who it was when we were growing up,” Kennedy said. “We’re going to be the most respected health agency in the world.”
The leadership departures comes at a tumultuous time for the agency, which is reeling from a gunman’s attack on its Atlanta headquarters on Aug. 8. A police officer died in the shooting.
— CNBC’s Angelica Peebles contributed to this report.
MORE IN INSIDE BUSINESS

Netflix stock sinks after streamer reiterates guidance, says Reed Hastings to exit board
Published: Friday, April 17, 2026 · 2:22 AM

Trump nominates Erica Schwartz as CDC director amid turmoil around leadership, vaccine policy
Published: Thursday, April 16, 2026 · 10:39 PM